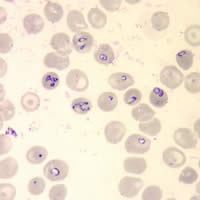
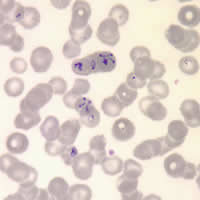
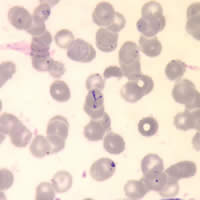
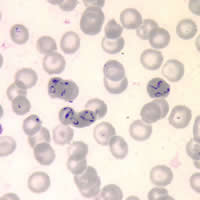

Case
75
A patient sought treatment for fever, fatigue, and myalgias.
She reported no recent international travel. Below are images of
Giemsa stained blood smears from the patient’s specimen (Figures A,
B, C, and D). What is your diagnosis?
Based on what criteria?
|
|
A |
B |
|
|
C |
D |
Click
here for the answer to Case 75.
Case
76
A child with nausea, anorexia, and explosive, watery
diarrhea was seen by a physician who ordered an O & P (ova and parasites)
stool examination. Below are images from a wet mount preparation
stained with Lugol’s iodine (Figure A) and from a trichrome stained smear of the
child’s stool specimen (Figures B, C, and D). The average size of the objects in
the images
was 13 µm in length and 8 µm in width. What is your diagnosis?
Based on what criteria?
 |
 |
A |
B |
 |
 |
C |
D |
Click
here for the answer to Case 76.
Images
presented in the monthly case studies are from specimens submitted for diagnosis or
archiving. On rare occasions, clinical histories given may be partly
fictitious.
|